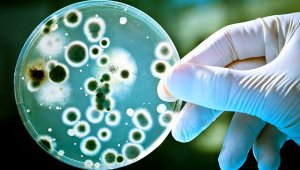
Según un amplio estudio publicado esta semana. Internet

Artículo
Google y la eficiencia en el teletrabajo
Millones de personas se encuentran teletrabajando debido a la cuarentena que se ha producido por la COVID-19.
Economía
EconomíaArtículo
Hay 41.000 personas más en Cúcuta
"El 38 % de los habitantes no nacieron en la ciudad", dice el Dane.
Vida y salud
Vida y saludArtículo
Bacterias podrían causar depresión
Esta “epidemia silenciosa” es una de las principales causa de suicidios registrados cada año, según la OMS.
Publicidad
Seguir leyendo
Publicidad
Publicidad
Publicidad